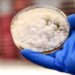
Crean carne para hamburguesas con hongos modificados genéticamente

(14 de marzo del 2024. El Venezolano).- Este jueves se ha aprobado en el Congreso de los Diputados de España la ley de amnistía para los involucrados en el ‘procés’ catalán.
La norma ha salido adelante en su segunda votación con el apoyo del Partido Socialista Obrero Español (PSOE), Sumar, Esquerra Republicana de Catalunya (ERC), Junts per Catalunya, Partido Nacionalista Vasco (PNV), EH Bildu, Podemos y Bloque Nacionalista Galego (BNG).
En contra han votado los diputados del Partido Popular (PP), de la ultraderecha de Vox y los únicos diputados de Coalición Canariai (CC) y Unión del Pueblo Navarro (UPN). En total, 178 votos afirmativos y 172 votos negativos.
Ahora el proyecto de ley pasará al Senado. Allí, el conservador Partido Popular (PP) tiene mayoría absoluta y recientemente reformó el reglamento de la Cámara para alargar los tiempos de tramitación de esta norma. Así, hasta dentro de dos meses la legislación no volverá al Congreso, donde será aprobada definitivamente.
La iniciativa fue presentada por el PSOE del presidente Pedro Sánchez después de que Junts se lo exigiera como requisito indispensable para apoyar su investidura.
Por su parte, los partidos de la oposición han criticado la medida duramente sosteniendo que no tiene encaje constitucional y que se trata de un ejercicio de corrupción política al indultar a unos políticos, refiriéndose principalmente al expresidente catalán Carles Puigdemont, a cambio de unos votos para mantenerse en el poder.
Así, ya se sabe que tanto el PP como Vox presentarán recursos de inconstitucionalidad ante el Tribunal Constitucional. Asimismo, se prevé que algunos jueces presenten cuestiones prejudiciales ante el Tribunal de Justicia de la Unión Europea.